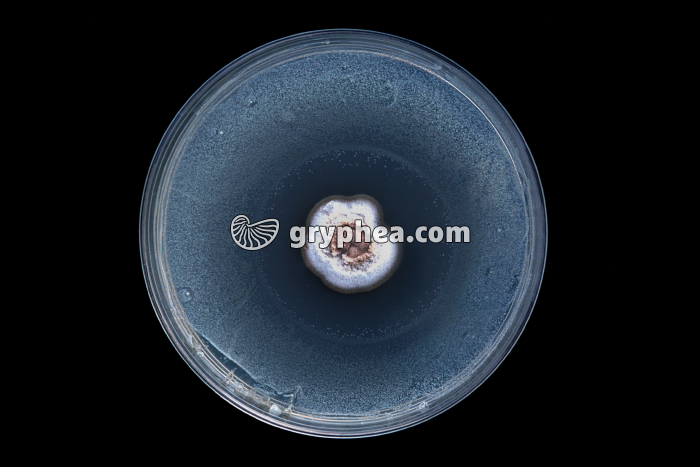
Expérience de Fleming - gryphea.com

Type : Photographie
Référence : K 12411b
Auteur : Hervé Conge
Edition et PresseNumérique et Internet
Valeur du crédit
1 crédit = 6.00€ TTC
(Hors pack)
1 crédit = 6.00€ TTC
(Hors pack)
si vous êtes enseignant, le site gryphea.org a été conçu spécialement pour vous !
Edition et Presse
Paramètres additionnels
Tirage
Distribution
Durée d'utilisation
Droits numériques en sus
Total : crédits
Ajouter au panier
Numérique et Internet
Paramètres additionnels
Numérique
Internet
Durée d'utilisation
Total : crédits
Ajouter au panier
Numérique et Internet
Paramètres additionnels
Numérique
Internet
Durée d'utilisation
Total : 4 crédits
Ajouter au panier
Informations :
Commentaire en cours de rédaction.
Thèmes associés :
Système immunitaire